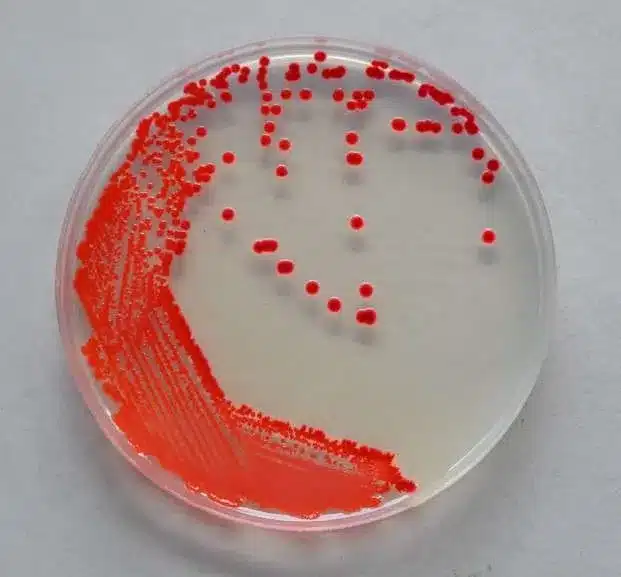

Alerte : Découvrez le danger caché derrière une substance rose dans votre salle de bain
Imaginez-vous sous la douche, apercevant une teinte rose suspecte près du siphon. Ce dépôt apparemment anodin cache en réalité une menace bactérienne insoupçonnée.
Une micro-organisme friand d’humidité

Malgré son apparence trompeuse, ce composé n’est en réalité pas un champignon, mais une micro-organisme connue sous le nom de Serratia marcescens selon les explications du Dr Karan Rajdans une vidéo sur Tiktok. Elle se développe principalement dans des environnements humides et contenant des résidus de produits de nettoyage ou de soins capillaires. Cette micro-organisme trouve donc dans la salle de bain un terrain propice pour se multiplier et former un film biologique rose ou rougeâtre.
Bien que son aspect puisse sembler inoffensif, elle n’est pas sans risques, surtout pour les individus fragiles.
Un risque potentiel pour la santé
Bien que cette micro-organisme ne présente généralement pas de danger pour les personnes en bonne santé, elle peut tout de même causer des infections si elle entre en contact avec une plaie ou les yeux. Chez les individus immunodéprimés ou hospitalisés, elle peut même déclencher des infections plus sévères telles que des infections urinaires, respiratoires ou gastro-intestinales. De plus, elle est souvent résistante aux antibiotiques, ce qui rend son élimination compliquée en cas d’infection.
Et ce n’est pas tout : la présence de Serratia marcescens peut indiquer un taux d’humidité élevé dans votre logement, un facteur favorisant également la croissance d’.
Comment se débarrasser efficacement de cette micro-organisme ?
Bonne nouvelle : en adoptant les bonnes pratiques, vous pouvez prévenir la prolifération de cette micro-organisme dans votre salle de bain.
- Aération et ventilation: Une bonne aération de la salle de bain est la meilleure arme contre cette micro-organisme. Ouvrez une fenêtre après chaque douche ou utilisez un ventilateur d’extraction pour éliminer l’humidité.
- Nettoyage régulier: Utilisez du vinaigre blanc, du bicarbonate de soude ou un produit désinfectant antibactérien pour nettoyer les zones à risque (joints, siphons, rideaux de douche).
- Évitez les résidus de produits de nettoyage: La micro-organisme se nourrit des dépôts graisseux laissés par les produits de nettoyage et de soins. Un nettoyage régulier des surfaces permet de limiter sa présence.
- Agissez rapidement face aux premiers signes: Dès que vous repérez des traces roses, nettoyez-les immédiatement. Plus vous tardez, plus la colonie microbienne se renforce et devient difficile à éliminer.
Ne laissez pas cette micro-organisme proliférer

Ignorer cette célèbre « boue rose » pourrait encourager sa propagation et, à terme, causer d’autres problèmes plus graves. Adopter quelques gestes simples d’entretien vous permettra de maintenir une salle de bain propre et saine.
Alors, lorsque vous repérez cette teinte rosée près de votre siphon, agissez rapidement : nettoyez sans tarder !
@dr.karanr Pink slime club @Anna ♬ original sound – Dr Karan Raj